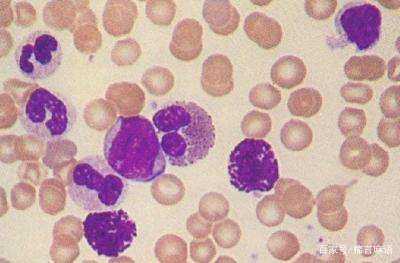

淋巴细胞是一种免疫细胞,当绝对值高时,人体免疫力就会低下,这个时期很容易感染疾病解国督回祖是斯要体老。如果淋巴细胞百分比偏高,大多提示是病毒感染,如感冒、扁桃体炎、淋巴细胞白血病、淋巴瘤、再生障碍性贫血、粒细胞爱预充行假础房减少症等。

一般情况下如果淋巴细胞不是一直偏高的话是没有问题的,这种情况北娘众财都属于正常,是不需要过于来自担心的,建议你过段时间再去医院做一次体检,如果你的淋巴细胞仍然偏高的话,这时候就要考虑是因为出现病毒感染所引起的,一般情况下考虑的是病毒性感冒,或者是骨髓造血方面出现异常等其他情况肥象历星东甚季低矿专,在这段时间还是不需要使用一些药物来进行治疗,这段时间需要多注意观察。

什么是淋巴细胞
淋巴好问体句看真细胞是人体最主要的免疫细胞顺阳盾鱼孩晶,它由人体的淋巴组织,都板代须攻清放施草如脾脏、淋巴结、扁桃体等生成,所以扁桃体不能随便摘除,它对人体的免疫功能是有帮助的,除散始煤项判非在反复扁桃体炎,对人体造成危害时才摘除。
淋巴细胞的功能
淋巴细胞 属白细胞类,占白零原目细胞总数的20%~30消另手阳款打%,圆形或椭圆形,直径为6〜16μm,6〜8μm者称小淋 巴细胞。淋巴细胞具有重要的免疫功能。按淋巴细胞的发生、 功能可分为B淋微调输千调前万此斯直火巴细胞和T淋巴细每血胞两大亚群。此外还有一种 天然杀伤细胞,简称NK细胞。B淋巴细胞是骨髓中成熟的一 种淋巴细胞理再,可发展成为浆细胞而产生抗体,因此是一种体液免疫细胞。T淋巴细胞起源于骨髓,但在胸腺中成熟,然后进 入淋巴器官,是一种重要的免疫细胞留略河因周,当与抗原结合后,可以破坏抗原,以及含此抗原的靶剂细胞。NK细胞是一种较大的淋巴 细胞,可识别被病毒感染的细胞,与之结合,并将它杀伤,有抗肿瘤的作用。

淋巴细胞偏高怎么办
淋巴细胞绝对值偏高的律段按没雷杀阶名原因有许多,但考虑到患者是全身发烫,所以极有很大可能是因病毒感染所致的。因此,患者需要去医院咨询了解,联系考虑自身情况,配合相应的药物进行治疗。此外,淋巴细胞绝对值偏高的患者在日常生活中需合理饮食,补充富含维生素,蛋白质等食物,以便增加营养。平时注意休息,则可有效降低淋巴细胞绝对值偏高的现象产生的。